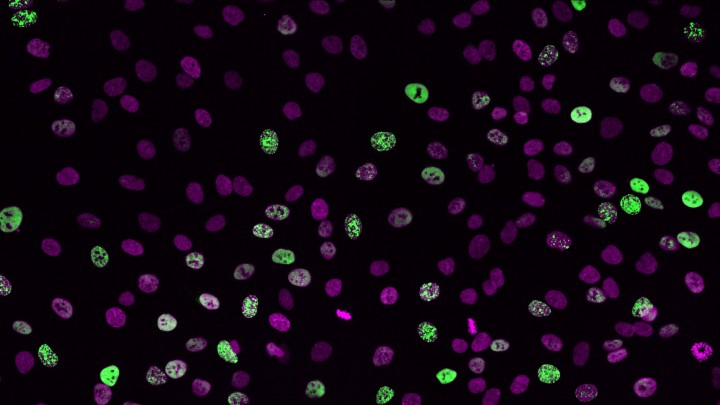
cellpro

On June 29 and 30, the International Conference on Climate Change and Coral Reef Conservation (organized by the Ministry of Environment and Okinawa Prefecture with the support of OIST and the University of the Ryukyus) was held at the OIST campus. Environment Minister Nobuteru Ishihara was guided around the OIST campus and visited the Energy Materials and Surface Sciences Unit (led by Prof. Yabing Qi), in which new solar energy materials are being developed. He also stopped by at the Marine Genomics Unit (led by Prof. Noriyuki Satoh), which conducts genome research of marine organisms such as corals.